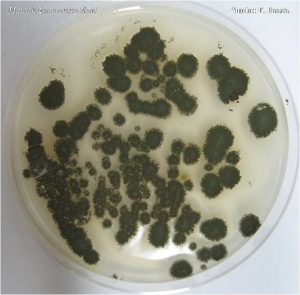

Producent Novozymes heeft besloten om met de productie van het biologische middel BIO1020 én MET52 OD te stoppen. Reden is dat het productieproces van de schimmel Metarhizium anisopliae stam F52 en de formulering van BIO1020 en MET52 OD uiterst complex zijn. Bayer levert sinds 2004 BIO1020, wat inmiddels een gewaardeerd product in de sector is voor de beheersing van enkele lastig te bestrijden bodeminsecten zoals de taxuskever. Bayer heeft de mogelijkheden onderzocht om de toekomst van BIO1020 veilig te stellen, maar dit is niet gelukt. Hierdoor stopt de levering van BIO1020. Het beschikbare product mag dit en volgend jaar opgebruikt worden.